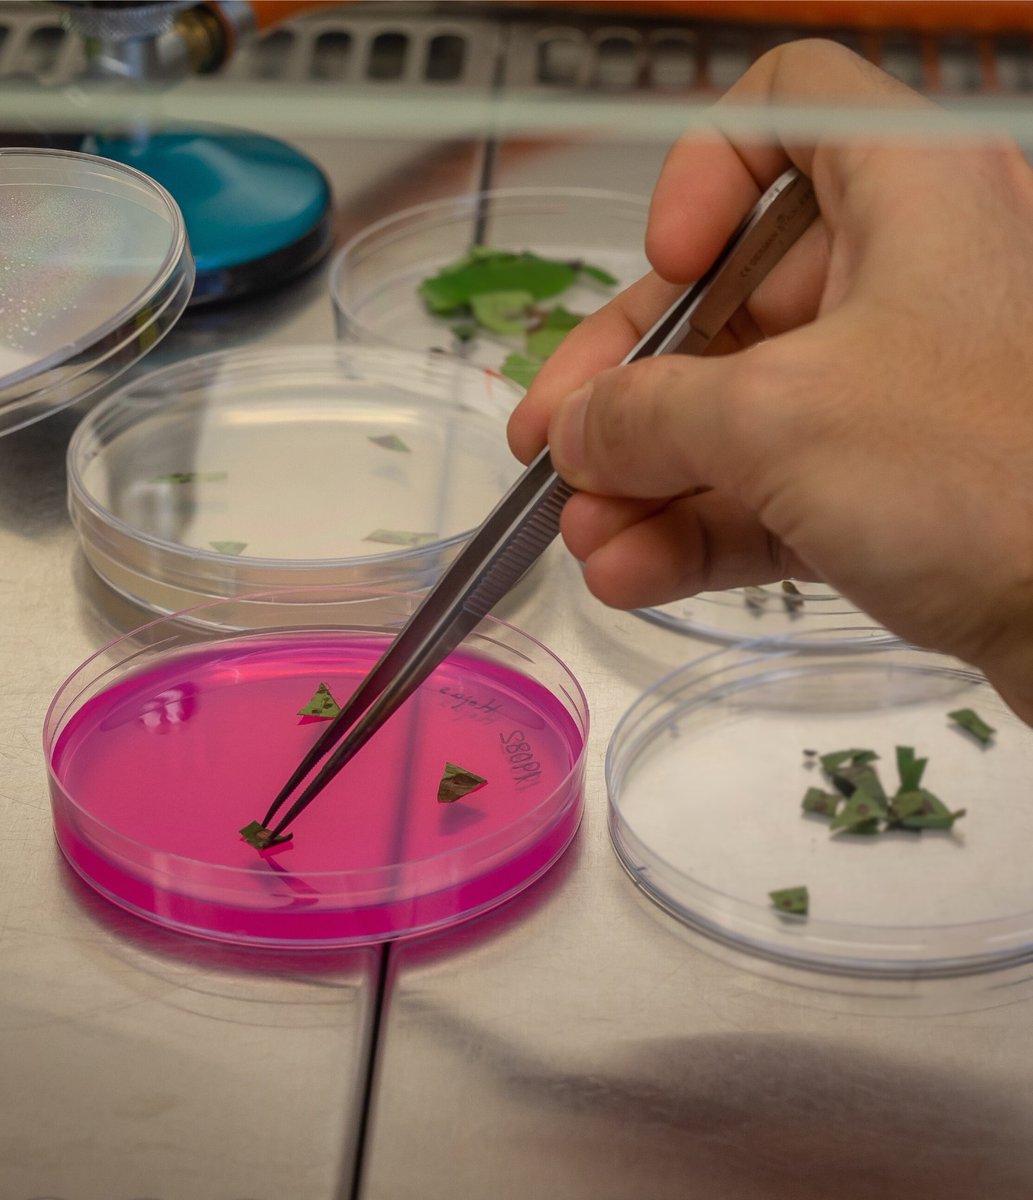
ValGenetics tweet media

ValGenetics
2.2K posts

ValGenetics
@valgenetics
🧬 Empresa biotecnológica que ofrece soluciones científicas al sector agrario
Comunidad Valenciana, España Katılım Mayıs 2017
4.4K Takip Edilen1.9K Takipçiler

Podéis contactar con nuestro equipo:
☎️ 960 059 146
📱 657 075 127
📧 comercial@valgenetics.com
¡Gracias por vuestra colaboración y felices Fallas! 🔥

Español

Hoy hemos asistido a la jornada informativa sobre el virus de la clorosis nervial amarilla de los cítricos (CYVCV), organizada por el @GVAivia
Desde ValGenetics creemos que la investigación en fitopatología es clave para garantizar la sostenibilidad del sector citrícola🌱🍋

Español

🚜🌱ValGenetics en FIMA Zaragoza
Hemos estado visitando #FIMA para conocer de primera mano las últimas innovaciones el sector agrícola.
Siempre es un placer descubrir cómo la biotecnología genera nuevas oportunidades en la agricultura✨

Español

Este #11F, nuestra CEO María Albiach participará en una mesa redonda junto a otras mujeres referentes del ámbito científico, compartiendo experiencia y vocación👩🔬✨
Una iniciativa orientada a visibilizar el talento, generar referentes e impulsar la igualdad en la ciencia🔬💜

Español

🌱✨¡Nuevo proyecto en marcha!
Gracias a la subvención de Generalitat Valenciana, IVACE y UE, desarrollamos GenoSystem Plant, una plataforma que optimiza los programas de mejora genética y diferenciación de variedades en cultivos clave🍈🍓
📰fito.valgenetics.com/genosystem_pla…
#innovalgen

Español

Participamos como colaboradores en el día de la Asociación Profesional de Flores, Plantas y Tecnología Hortícola de la Comunidad Valenciana @asfplant. Desde ValGenetics, damos soporte a la calidad fitosanitaria de la planta de vivero mediante técnicas moleculares.🫒🧬🔬

Español

🌱 Del suelo como gran desconocido a correlacionar genética vegetal, ambiente y microbiota en busca de una agricultura sostenible.
🔬 #ValGenetics presente en la 4ª edición de #Microbioma, para compartir conocimiento en microbiología, ómicas y fisiología vegetal.

Español

👏 ¡Un placer asistir a la Nit Biotec de @BIOVAL_es!
✨ Enhorabuena a todos los premiados, especialmente a Kristin Suleng (@parccientificuv) por su labor en divulgación científica.
🔬 Gracias por dar voz a los avances biotecnológicos y al trabajo de ValGenetics

Español

🌿 ¿Sabes qué es el evento @Iberflora?
Se trata de una de las ferias más importantes del sector verde que reúne a profesionales de la jardinería, la horticultura ornamental y el paisajismo
💡 ValGenetics visitará Iberflora para intercambiar conocimiento en genética y sanidad

Español